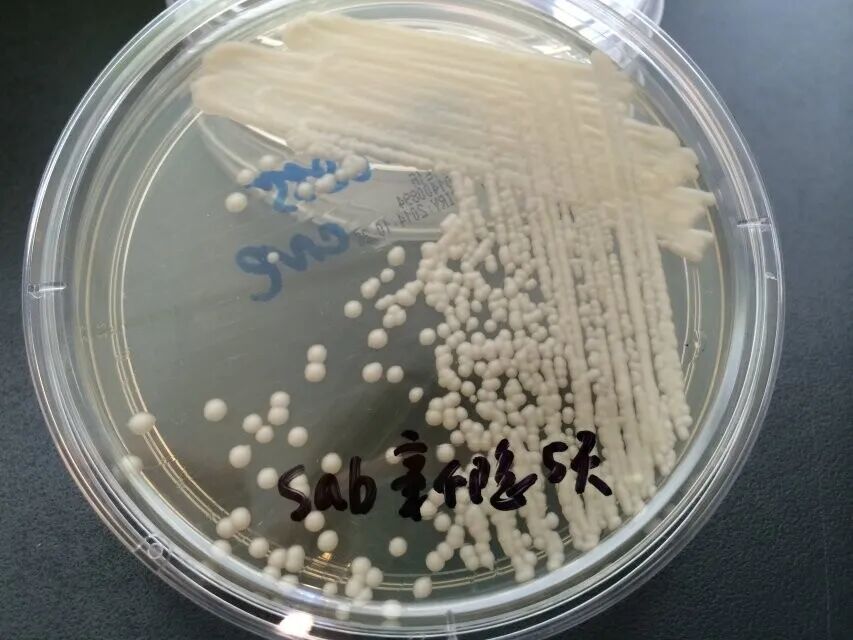
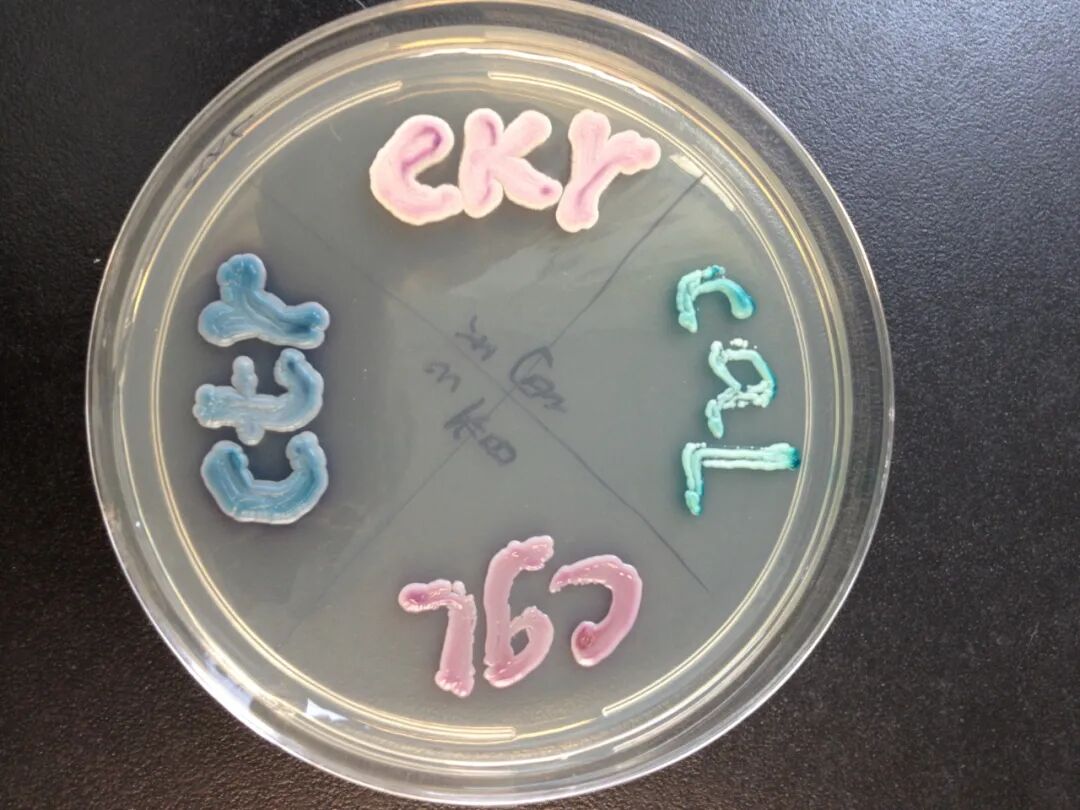
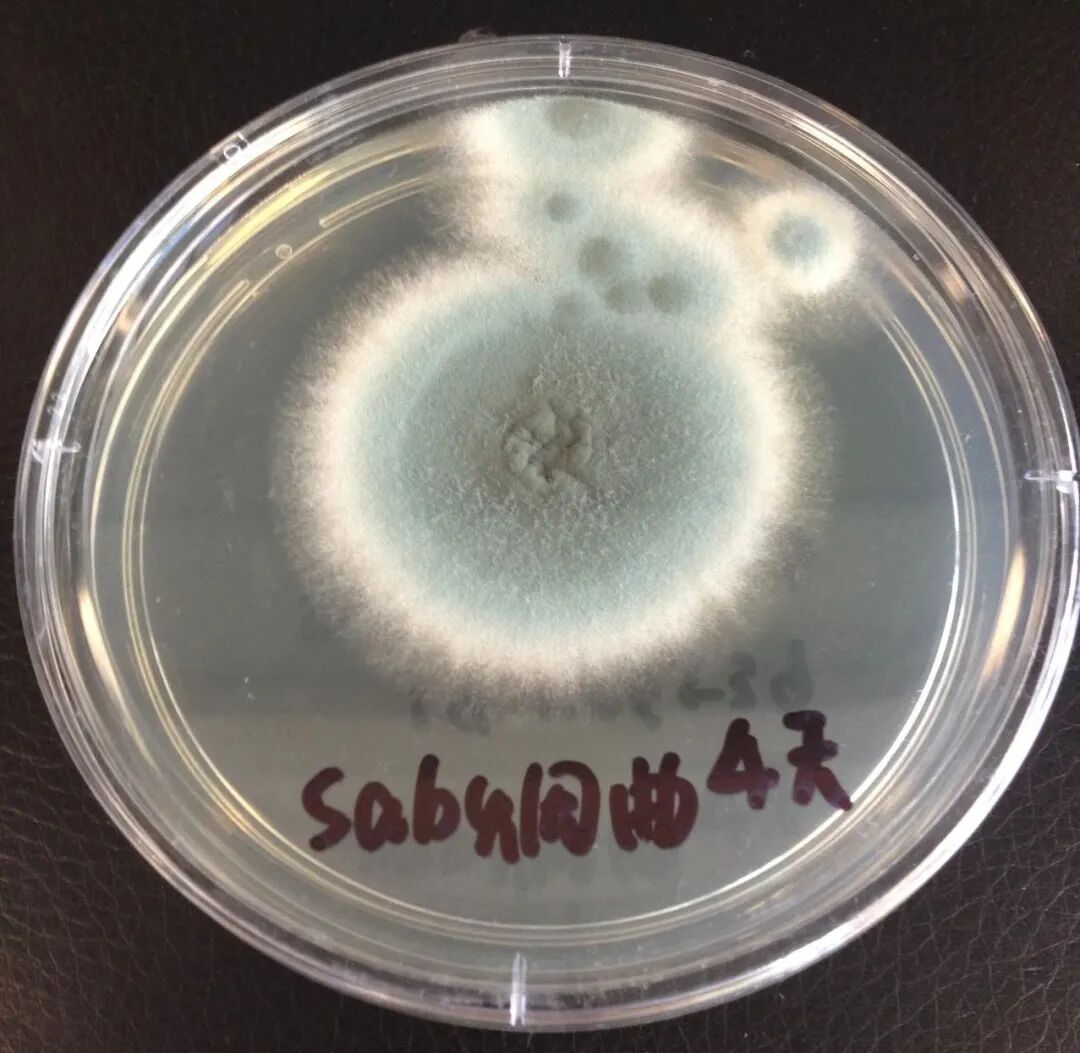
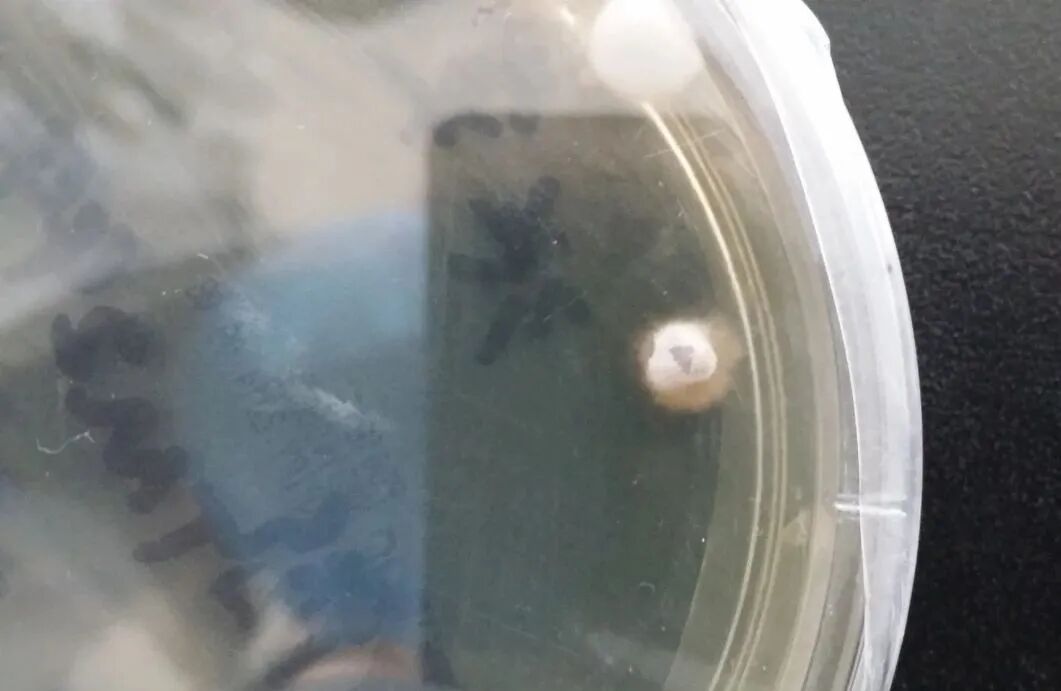

真菌可分为单细胞和多细胞两大类。基于真菌菌落形态可简单分为酵母型菌、类酵母型菌、丝状型菌和双相真菌。
1、酵母型菌通常为单细胞,圆形或卵圆形,以母细胞产生芽孢而繁殖,产生芽生孢子,不形成真、假菌丝,有子囊或无子囊,不形成有性孢子。菌落为乳酪样,隐球菌属此群。
新生隐球菌
2、类酵母型菌似酵母,以出芽方式繁殖,无子囊,可有真、假菌丝,念珠菌属此群。
念珠菌
3、丝状型菌为多细胞,可产生分支的菌丝,菌丝交错形成浓密丝状团,成为菌丝体。菌落呈棉花状、绒毛状或粉末状,这种丝状的真菌具有营养菌丝和气生菌丝,曲霉属此群。
烟曲霉
4、双相真菌既能以酵母相又能以菌丝相存在,35-37℃培养或宿主组织内为酵母相,而菌丝相见于25-28℃培养物内,马尔尼菲篮状菌、粗球孢子菌、副球孢子菌、组织胞浆菌、申克孢子丝菌即属于此群。
组织胞浆菌
很多真菌可以产生多种颜色的色素,使菌落表面和背面呈现不同颜色,有的分泌可溶性色素还可深入培养基中。部分真菌培养一定时间还可产生黏液珠、菌核等特殊结构。真菌菌落形态、颜色、特殊结构对丝状真菌的鉴定起到关键作用。
卢洪洲 钱雪琴 徐和平 《医学真菌检验与图解》
徐英春 《临床真菌学图谱》
图片来源 王贺